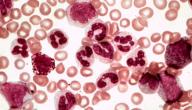

مرض السرطان
يُعد مرض السرطان من الأمراض الشائعة في الوقت الحاضر، وخاصة مع وجود الملوثات البيئية، وانتشار الأشعة الخطيرة التي تتسبب بزيادة مخاطر الإصابة بالمرض، وانتشار الوجبات السريعة المعزّزة لحدوث السرطان، ووجدت الدراسات أنّ الولايات المتحدة الأمريكية وحدها، لوحظ فيها إصابة شخص واحد من بين ثلاثة أشخاص بأحد أنواع مرض السرطان، وعلى الرغم من هذا الانتشار، فقد تطوّر العلم بدرجةٍ كبيرة، وأصبح من الممكن الوقاية من المرض، وذلك عبر التعرف على أسباب المرض وتجنبها، وقد تمكن بعض الأطباء من علاج السرطان وتشخيصه لأغلب أنواعه، كما جرى تعريف الأشخاص بأنماط العيش التي تساعدهم في حماية أنفسهم من هذه الآفة، هنا، سيتم التعرف على أهم أسباب مرض السرطان، كما سيتم توضيح أبرز أعراضه.[١]
أعراض مرض السرطان
تختلف أعراض مرض السرطان من شخص لآخر باختلاف عدة عوامل كجنس المريض، صحته العامة، وهذه الأعراض قد تكون المؤشر لمعرفة أسباب مرض السرطان، كما تختلف الأعراض تبعًا للجزء المصاب، وقد تتضمن أعراض وعلامات مرض السرطان المتنوعة على سبيل المثال ما يأتي:[٢]
- تغيرات في أداء الجهاز الهضمي والمثانة: فقد يُلاحظ حدوث عسر في الهضم، كما قد يحدث عدم راحة بعد تناول الطعام.
- وجود صعوبة في عملية التنفس والبلع: كما قد يلاحظ تغير الصوت بالتزامن مع السعال البحة.
- وجود بعض التغيرات في الجلد: مثل اصفراره أو احمراره، وقد تحص بعض التقرحات والندب، وانتشار الشامات.
- الشعور بوجود كتل سميكة تحت الجلد.
- حدوث النزيف والكدمات بدون مسبب خارجي ظاهر.
- وجود آلام في العضلات والمفاصل بصورة غير مبررة.
- قد يُلاحظ أيضًا ارتفاع درجات الحرارة وحدوث التعرق الليلي.
أسباب مرض السرطان
تختلف أسباب مرض السرطان باختلاف العضو المصاب، لكن عمومًا، ينشأ السرطان من تحول الخلايا التي تعمل بشكل طبيعي إلى خلايا سرطانية، وتتم عمليّة التحول عادةً بواسطة مراحلٍ عديدة، وينشأ هذا التحول عادةً بسبب العوامل الوراثية والعديد من العوامل الأخرى، ومن هذه العوامل:[٣]
- التعرض للمواد الفيزيائية المسرطنة: مثل الإشعاعات الأيونية والأشعة فوق البنفسجية.
- التعرض لبعض المواد الكيميائية: مثل السجائر، الزرنيخ، وغيرها من المواد.
- قد تتسبب بعض العوامل البيولوجية: في الإصابة بمرض السرطان، مثل الفايروسات والطفيليات والبكتيريا.
- تقدم العمر: وذلك بسبب قلة فاعلية عمليات الإصلاح الخلوي التلقائية، والتي تمنع تحول الخلايا الطبيعية إلى خلايا سرطانية.
- الممارسات والعادات التي يقوم بها البعض: مثل تناول المشروبات الكحولية، التدخين، سوء التغذية، الخمول البدني، عدم ممارسة التمارين الرياضية وغيرها من العادات، تعد من أبرز أسباب مرض السرطان.
- بيئة العيش: قد تؤثرعلى معدل الإصابة بالسرطان، ففي البللدان ذات الدخل المتدني، تبرز الكثير من السرطانات، إضافة للفيروسات التي تعزز الإصابة بالسرطان، مثل فيروس التهاب الكبد الوبائي C أو B، والذي يتسبب بزيادة خطر الإصابة بسرطان عنق الرحم، وسرطان الكبد.